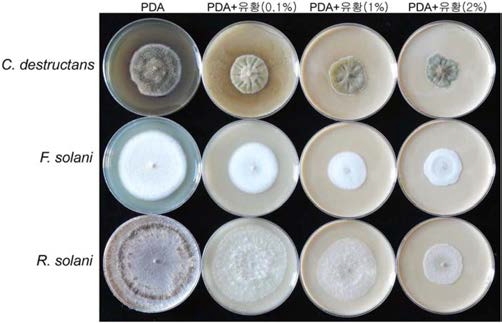
Fig. 1.

파종전 무기유황 관주처리가 묘삼의 생육 및 뿌리썩음병 발생에 미치는 영향
© The Korean Society of Medicinal Crop Science
This is an Open-Access article distributed under the terms of the Creative Commons Attribution Non-Commercial License ( http://creativecommons.org/licenses/by-nc/3.0 ) which permits unrestricted non-commercial use, distribution, and reproduction in any medium, provided the original work is properly cited.
Abstract
To control the disease of root rot in ginseng nursery, inorganic sulfur solution of 0.1%, 1.0%, and 2.0% were irrigated by amount of 10 ℓ per 3.3 m2 before sowing. On the last ten days of July, Fusarium solani and F. oxysporum were similarly detected by 44.8% and 43.8%, respectively, while Cylindrocarpon destructans was low detected by 4.4% in the diseased seedling. The more sulfur’s concentration was increased, the more soil pH was decreased. Soil pH was decreased from 5.87 to 4.59 by the irrigation of sulfur solution of 1.0%. The more sulfur’s concentration was increased, the more electrical conductivity (EC) of soil was increased. EC was increased from 0.27 dS/m to 1.28 dS/m by the irrigation of sulfur solution of 1.0%. Irrigation of sulfur solution was effective on the inhibition of damping-off caused by Rhizoctonia solani in ginseng seedling. Control value for damping-off by the irrigation of sulfur solution of 1.0% and 2.0% were 75.7%, and 78.5%, respectively. Growth of leaf was inhibited by the irrigation of sulfur solution of 2.0%. Root weight per 3.3 m2 showed the peak in sulfur solution of 1.0%, while survived-root ratio and root weight per plant were decreased in the level of 2.0%. Survived-root ratio of seedling in sulfur solution of 1.0% was distinctly increased by 4.7 times compare to the control, but control value for root rot was relatively low as 49.2%. Mycelium growth of C. destructans, F. solani, and R. solani were distinctly inhibited by the increase of sulfur’s concentration in vitro culture using PDA medium.
Keywords:
Inorganic Sulfur, Panax ginseng, Root Weight, Seedling, Soil-Borne Pathogen서 언
인삼의 연작장해는 뿌리를 썩게 만드는 토양전염성 병원균 인 Cylindrocarpon destructans, Fusarium solani, Rhizoctonia solani 등과 기타 병해가 복합적으로 관여하여 일어나는데, 그 중에서도 강한 병원성과 침입력을 가진 C. destructans에 의한 1차 감염이 연작장해의 가장 중요한 원인이다. (Park et al., 1997; Kang et al., 2007). 또한 인삼에서 뿌리썩음병에 관여 하는 병원균은 주로 C. destructans, F. solani와 R. solani인 데, 이병 뿌리조직에서 분리된 병원균 중에서 C. destructans 와 R. solani는 병원성이 매우 강하고 F. solani는 병원성이 약한 것으로 알려져 있다 (Kim et al., 1997; Punja, 1997).
C. destructans는 주로 고려인삼, 미국삼, 일본삼을 비롯하여 알팔파, 스위트 클로버, 연, 벗풀, 당근, 시크라멘, 떡갈나무, 감자, 전나무, 모란, 사과나무류, 배나무류 등과 같은 수목이나 초본성 식물에서 뿌리를 부패시키는데 (Booth, 1966), 생육최 적온도는 20°C이고 최적 pH는 4.0 ~ 5.0의 범위이다 (Cho et al., 1995).
인삼 뿌리썩음병을 일으킨 이병부위와 근권 토양에서 Fusarium균 (115균주)을 분리하여 동정한 결과 F. solani (55 균주), F. oxysporum (35균주), F. moniliforme (10균주), 그리 고 F. roseum (15균주) 등이 분리되었는데, 이중 F. solani만 병원성을 나타냈으나 C. destructans보다 병원성이 약하다고 하였다 (Lee, 2004). R. solani는 이른 봄 저온에서 잘록병을 일으키는데, 인삼 이외에 무, 배추, 양배추를 포함하는 십자화 과 작물과 상추, 아욱, 고추, 딸기 등에도 병을 일으키며, 생육 최적온도는 22 ~ 26°C 이고 최적 pH는 4.5 ~ 5.8이다 (Cho et al., 2004).
인삼의 뿌리썩음병은 병을 일으키는 기주범위가 넓고 인삼 과 같은 기주식물이 없어도 토양 속에서 수년간 생존하므로 방제가 곤란하다. 실제 토양 전염성 병해를 방제하기 위해서 는 화학농약을 다량 사용해야 하는데, 이로 인해 농약잔류의 위험이 크므로 실용적인 방제가 곤란하다. 따라서 윤작 등 경 종적 방제나 길항미생물, 유황 등과 같은 친환경 제제를 이용 하여 방제하는 방법이 합리적이라고 할 수 있다.
황 (sulfur, S)은 식물의 필수다량원소이며, 식물체에는 인산 과 비슷한 수준으로 0.1% ~ 1.0% 정도 함유되어 있다. 토양 중의 황은 원소 상태로 퇴적되어 있거나 화성암에 0.05 ~ 0.3% 정도 황화물의 형태로 존재하는데, 호기적 조건에서 풍화되거 나 토양미생물에 의해 산화, 분해되어 2가의 황산염 음이온 (SO42−) 형태로 식물에 흡수되며, 또한 화석연료가 연소될 때 발생하는 이산화황 (SO2)과 황화수소 (H2S)가 비에 섞여 식물 생장에 이용되기도 한다 (Ryu, 2000).
무기유황은 친환경 유기농 자재로 이용되며, 살균, 살비효과 가 있을 뿐 아니라 식물의 생육을 촉진하는 작용을 하는데, 화학농약에 저항성을 보이는 잿빛곰팡이병, 탄저병 등을 방제 하기 위해 유황을 토양에 처리한 결과 균사생장 억제효과는 적으나 포자발아 억제효과가 매우 크다고 보고되었으며 (Kwak et al., 2012a,b), 유황처리로 토양 pH가 저하되어 감자 더뎅이 병의 발생이 억제되었다고 하였다 (Kim et al., 2012). 또한 토양에 유황을 처리하면 열무에서 생육이 억제되나 석회로 토 양을 중화시키면 수량이 증가되었으며 (Kim et al., 2004), 양 파에서 유황 처리가 칼슘, 철 등 무기성분 함량을 증가시키고 기능성 성분 (thiosulfinate)의 함량을 증가시켰다고 하였다 (Choi and Surh, 2013).
최근 인삼의 뿌리썩음병을 방제하기 위해 유황을 예정지 토 양에 사용하는 농가가 늘어나고 있어 유황에 대한 인삼 뿌리 썩음병 방제 효과의 검증이 필요하나 이에 대한 연구결과는 아직 없는 실정이다. 따라서 본 연구에서는 인삼종자를 파종 하기 전 예정지 토양에 유황을 농도별로 관주 처리하여 인삼 의 입고병이나 뿌리썩음병 방제에 효과가 있는지를 구명하기 위해 수행하였다.
재료 및 방법
본 실험은 충북 음성 소재 국립원예특작과학원 인삼특작부 시험포장에서 2011년 11월부터 2012년 11월까지 수행되었다. 시험품종은 인삼 재래종인 자경종 이었으며, 2011년 7월 하순 에 4년생 본포에서 채종한 다음 개갑 처리를 시작하여 11월 상순에 개갑이 완료된 종자를 사용하였다.
이병토양을 조성하기 위해 2011년 10월 하순경 연작장해 발 생이 심하여 중도에 포기한 농가포장의 토양을 옮겨와 0.5m 높이로 성토하여 재작지와 비슷한 토양환경의 시험포장을 조성 하였다. 해가림 시설로 단동 비닐하우스 (폭 7 m, 높이 3 m, 길 이 70m)를 설치하였고 흑색 2중직 차광망 (투광율 15% 내외) 을 피복하였다.
인삼종자를 파종하기 전인 2011년 11월 하순경에 무기유황 (쿠무러스 입상수화제, 성보화학)을 0.1%, 1.0%, 2.0% 수용액 으로 만들어 상면에 칸 (3.3m2)당 5리터씩 1주일 간격으로 총 2회 관주하였다. 즉, 11월 21일에 1차 관주한 후 토양을 뒤집 고 1주일 후에 2차 관주를 하여 토양소독처리를 하였다.
파종은 2차 관주처리 1주일 후인 12월 5일에 하였으며, 파 종밀도는 3.5 × 3.0 cm로 3.3m2당 1,500립을 파종하였다. 시험 전 토양 화학성은 Table 1과 같은데, 유기물 함량이 다소 낮 았으나 기타 성분은 인삼재배에 적합한 수준이었다. 시험구 면 적은 처리구당 6.6m2이었으며, 난괴법 3반복으로 배치하였다. 토양분석은 2012년 5월 상순 시료를 채취하여 국립농업과학원 의 토양화학성 분석방법 (NIAST, 2000)에 준하여 분석하였다.
토양수분을 적절히 공급해 주기 위해 연간 4회 고랑에 관수 를 하여 토양수분 함량을 18% 내외로 조절하였다. 비닐하우 스 재배는 강우가 차단되어 점무늬병, 탄저병 등 지상부 병해 발생이 적었기 때문에 (Lee et al., 2011) 지상부 병해 방제는 별도로 하지 않았다.
시험포장에서 토양전염성 병원균의 오염 정도를 조사하기 위해 2012년 7월 중순경 무처리구에서 생육중인 묘삼을 채취 하여 병원균의 발생 여부를 확인하였다. 채집한 인삼을 멸 균증류수로 깨끗이 씻은 후 이병 조직을 잘라 1% sodium hypochlorite에서 2분간 표면 살균하였다. 표면 살균한 이병 조 직은 멸균수로 3회 세척하고 멸균된 여과지 (Whatman No. 1) 로 물기를 제거한 후 streptomycin (600μg/mℓ)이 첨가된 감자 한천배지 (potato dextrose agar, PDA)에 치상하여 25°C 항온 기에서 5일간 배양하였다. 치상한 이병 조직에서 자라난 균사 의 선단 부분을 떼어서 PDA 배지에 재배양하였다. 분리된 균 은 water agar, V8 agar 배지 등을 이용해 단포자 분리를 실 시해 생리 및 형태가 동일한 균주를 선별하였다.
분리된 균주의 분자생물학적 동정을 위해 complete media agar 배지에서 7일간 배양한 후 CTAB buffer (Proctor et al., 1995)를 이용해 genomic DNA를 추출하였다. rDNA의 증폭을 위해 ITS1 (5'-TTCGTAGGTGAACCTGCGG-3'), ITS4 (5'-A ACATGCGTGAGATTGTAAGT-3') primer set을 사용하였고 전기영동 확인 후 염기서열을 분석하였다. 모든 순수 분리된 균은 15% 글리세롤 용액에 현탁하여 −70°C 초저온 냉동고에 보관하여 사용하였다.
인삼의 토양전염성 병원균 3종 (C. destructans, F. solani, R. solani)의 균사생장에 미치는 무기유황의 영향을 조사하기 위해 PDA 배지에 무기유황을 0.1%, 1.0%, 2.0% 농도로 첨 가하고 배지 중앙에 접종한 후 항온기에서 배양하면서 균총의 직경을 경시적으로 측정하였으며, 각 실험은 3반복으로 수행 되었다.
무기유황 관주처리에 따른 묘삼의 지상부 생육특성은 2012 년 6월 하순경에 조사하였다. 묘삼 잎에 생기는 갈반형 황증 발생율은 황증 발생개체를 조사하여 백분율로 표시하였다. 묘 삼 지하부 생육 및 수량성은 2012년 11월 상순경에 조사하 였다. 묘삼의 지하부 병해 방제가는 [1-(처리별 병 발생율/무 처리 병 발생율)] × 100을 이용하여 구하였다. 통계처리는 SAS 프로그램 (SAS 9.2, SAS Institute Inc., Cary, NC, USA)을 이용하여 분석하였다.
결과 및 고찰
1. 이병 묘삼에서 검출된 뿌리썩음 병원균 종류
인삼 재작지 토양을 옮겨와 인위적으로 조성한 시험포장에 서 뿌리썩음병 증상을 보인 묘삼을 채집하여 병원균을 동정한 결과는 Table 2와 같다. 7월 하순에 무처리구에서 채집한 시 료의 이병부위에서 뿌리썩음병을 일으키는 F. solani가 44.8% 검출되었고 C. destructans는 4.4% 검출되었다. 그리고 인삼에 서 식물 내생균으로 알려진 F. oxysporum은 43.8% 검출되었 으며 (Lee, 2004), 기타 동정할 수 없는 곰팡이 종류가 7.0% 검출되었다. 따라서 재작지 토양을 이용하여 인위적으로 조성 한 시험포장에서는 인삼 뿌리썩음병을 일으키는 F. solani와 C. destructans가 오염되어 있다는 것을 알 수 있었다. Lee(2004)와 Punja (1997)에 의하면 인삼의 연작장해를 일으키는 주원인이 되는 뿌리썩음병의 병원균은 C. destructans 이나 대 부분 이병된 뿌리에서 F. solani도 같이 검출되는데, 이는 병 원성이 강한 C. destructans가 먼저 감염된 후 F. solani가 감 염되어 뿌리썩음병 증상이 더 악화되기 때문이라고 보고하 였다. 그리고 이병부위에서 F. solani가 C. destructans보다 더 높은 비율로 검출되었던 것은 7월 하순경의 지온이 25°C를 상 회하여 20°C 내외의 저온에서 잘 자라는 C. destructans보다 25°C의 고온에서 잘 자라는 F. solani가 우점되었기 때문으로 생각된다 (An et al., 2013; Park et al., 1997; Shin et al., 2012). 일반 토양에서 많이 검출되는 Rhizoctonia solani 는 생육초기인 4월 하순5월 상순에 줄기 지제부에 침투하여 인삼의 모잘록병을 일으키는데, 본 시험에서와 같이 7월 하순 에 이병된 묘삼의 뿌리를 조사한 결과 R. solani 병원균은 검 출되지 않았지만 토양에서는 존재할 것으로 생각된다 (Cho et al., 2004).
2. 유황 농도별 토양의 화학성의 변화
Table 3에서와 같이 유황 수용액을 농도별로 파종전 관주 처리하여 토양의 pH와 염류농도를 조사한 결과, 토양 pH는 유황의 농도가 높아질수록 뚜렷이 감소하였다. 즉, 무처리의 pH 5.87은 유황 2.0% 수용액을 칸 (3.3m2)당 5리터씩 2회 관주했을 때 4.08로 감소하여 토양산도가 1.79 정도 내려가는 효과를 보였다. 유황 수용액 관주로 토양 pH가 내려갔던 원인 은 유황이 물에 녹을 때 생기는 수소이온 (H+)의 증가 때문으 로 보인다. 인삼에서 적절한 토양산도는 pH 5.0 ~ 6.0이고 5.0 이하와 6.5 이상에서는 생리장해가 발생한다고 하였는데 (RDA, 2009), 본 실험에서와 같이 유황 1.0% 이상의 수용액 을 관주하면 토양산도 저하로 산성장해가 발생할 수 있기 때 문에 산도저하를 막기 위해 석회를 병용하는 것이 필요할 것 으로 생각된다. Kim 등 (2004)도 유황의 토양 처리시 석회를 시용하여 토양을 중화하면 열무의 생육이 촉진되었다고 하였다.

Changes of soil pH and EC by the concentration of sulfur treatment before sowing in ginseng nursery.
염류농도는 유황 수용액의 농도가 높아질수록 뚜렷이 증가 하였는데, 수소이온 (H+)과 황산이온 (SO42−), 그리고 유황에 섞인 불순물 등이 염류농도를 증가시킨 원인으로 생각된다. 인 삼에서 적절한 토양염류농도는 0.5 dS/m 이하이며, 1.0 이상에 서는 염류장해가 발생될 수 있다고 하였는데 (RDA, 2009), 유황 1.0% 수용액을 관주하면 염류농도가 1.0을 초과하여 염 류장해를 일으킬 수 있으므로 염류농도 증가에 주의해야 할 것으로 생각된다.
토양 염류농도를 증가시키는 주요 무기성분은 질산태질소, 마그네슘, 나트륨, 인산 등이라고 하였는데 (Hyun et al., 2009), 본 실험에서 Table 2와 같이 유황 농도가 증가할수록 염류농도가 증가되었던 것은 황산이온 이외에 추가로 질산태 질소와 인산 함량이 증가되었기 때문으로 보인다. 유황 수용 액 관주에 따라 질산태질소, 인산 함량은 다소 증가되었으나 칼륨, 칼슘, 마그네슘 함량은 무처리와 큰 차이를 보이지 않 았다.
3. 유황 수용액 관주에 따른 묘삼의 생육 및 지하부 병 발생 억제 정도
Table 4에서와 같이 파종전 유황 수용액 관주에 따른 묘삼 의 지상부 생육특성을 조사한 결과, 경장은 0.1% 유황을 관주 하면 무처리보다 증가되었으나 유황의 농도가 증가함에 따라 차차 감소되었다. 엽장은 유황 1.0% 수준까지는 무처리와 차 이가 없었으나 유황 2.0% 처리에서는 무처리보다 감소되었다. 엽폭은 유황을 처리하면 대체로 무처리보다 약간 감소되는 경 향을 보였다. 이와 같이 엽면적은 유황을 처리하면 약간 감소 되었는데, 유황 1.0% 수준까지는 엽면적의 감소 정도가 약했 으나 유황 2.0% 처리에서는 엽면적의 감소가 뚜렷하였다.

Growth characteristics of the aerial part of seedling by the concentration of sulfur irrigated before sowing in ginseng nursery.
잎에 생기는 황증은 유황의 농도가 증가됨에 따라 차차 증 가되어 유황 1.0% 처리에서 20.1%로 최고를 보였으나 특이하 게 유황 2.0% 처리에서는 황증이 전혀 발생되지 않았다. 유황 2.0% 처리에서는 Table 3과 같이 토양산도가 4.08까지 감소되 고 염류농도가 2.41 dS/m까지 증가되었으나 황증이 전혀 발생 되지 않았는데, 황증 발생은 주로 토양산도의 감소 (Lee et al., 2013, 2014)나 염류농도의 증가 때문이라는 보고 (Hyun et al., 2009)와 약간 다른 결과를 보여 금후 유황농도, pH, EC와 황증 발생의 관계에 대한 자세한 검토가 필요할 것으로 보인다.
유황 수용액의 농도별 처리에 따른 엽록소 함량을 보면 유 황 0.1%, 1.0% 수준에서는 무처리보다 약간 감소되었는데, 이 는 잎에 황증이 발생되었기 때문이었다. 유황 2.0% 처리에서 는 잎에 황증이 발생되지 않아 엽록소 함량이 무처리보다 약간 증가되었는데, 이는 황이 엽록소-단백질 복합체 형성에 영향을 미쳐 황증 발생을 억제했기 때문으로 판단된다 (Hong, 2012).
6월 하순경 입모율을 조사한 결과 유황 농도가 증가할수록 입모율이 뚜렷이 증가되었고 방제가는 유황 1.0, 2.0% 농도에 서 각각 75.7%, 78.5%로 생육초기 입고병 발생 억제에 효과 가 있었다. R. solani는 묘삼의 생육초기 입고병을 일으켜 입 모율을 낮추는데 (Cho et al., 2004), 그림 2와 같이 실제 유 황을 처리한 기내실험에서도 유황은 입고병을 일으키는 R. solani의 균총 생장을 뚜렷이 억제하였다.
Table 5에서와 같이 파종전 유황 수용액의 관주처리에 따른 묘삼의 지하부 생육특성 및 병해 발생 억제 정도를 조사한 결 과, 지하부 생존율은 유황 수용액 관주에 따라 무처리보다 뚜 렷이 증가되어 병해 발생 억제에 효과가 있었다. 즉, 무처리에 서의 지하부 생존율은 11.6% 이었으나 유황 1.0% 수준에서는 55.1%로 크게 증가되었다. 그러나 유황의 농도가 2.0%로 증 가되면 지하부 생존율은 다시 39.0%로 감소되었는데, 이는 토 양 pH의 감소와 염류농도의 급격한 증가가 뿌리썩음병 발생 에 영향을 미친 것으로 판단된다 (Rahman and Punja, 2005; Shin et al., 2012). 유황 수용액 관주에 따른 지하부 병해의 방제가는 1.0% 수준에서 49.2%로 가장 높았으나 일반적으로 낮은 수준을 보였다. 묘삼의 지하부 생존주수는 유황 1.0% 처 리에서 칸당 827개로 가장 많았으나 유황 2.0% 처리에서는 586개로 감소하였다. 묘삼의 지하부에 전혀 병반이 없는 건전 한 묘삼수도 유황 1.0% 처리에서 칸당 253개로 가장 많았으 나 유황 2.0% 처리에서는 140개로 감소되었다. 주당근중은 모 든 유황 처리구에서 무처리보다 증가되었는데, 유황 1.0% 처 리에서 최고를 보였으며, 유황 2.0% 처리에서는 감소되는 경 향을 보였다. 유황 1.0% 처리에서 주당근중이 최고를 보였던 원인은 지상부 생존율의 증가로 잎이 오래 보존되었기 때문이 며, 유황 2.0% 처리에서 주당근중이 다소 감소된 원인은 엽면 적의 감소 때문으로 생각된다. Lee 등 (2007)에 의하면 묘삼 재배에서 잎의 생존율과 생존기간은 뿌리비대에 가장 큰 영향 을 미친다고 하였으며, Lee 등 (2012)도 인삼 수량의 감소는 엽면적의 감소와 관계가 크다고 하였다 칸당 생근중은 지하부 생존율과 주당근중이 최고를 보인 유황 1.0% 처리에서 가장 많았으며, 유황 2.0% 처리에서는 감소되었는데, 이는 지하부 생존율과 주당근중의 감소 때문으로 보인다.
4. 기내에서 유황 농도별 병원균의 생육 억제 정도
Fig. 1과 같이 PDA 배지에 유황을 농도별로 처리하여 인삼 의 주요 토양병원균인 뿌리썩음병원균 (C. destructans, F. solani)과 모잘록병원균 (R. solani)의 균총 직경을 조사한 결과, 인삼 뿌리썩음병원균과 모잘록병원균 모두에서 유황의 농도가 증가함에 따라 병원균의 생장억제 효과가 뚜렷하였다. Fig. 2 에서와 같이 인삼 뿌리썩음병의 원인균인 C. destrucrans와 F. solani는 최초 접종 후 7일째에 균사의 생장이 대조구에 비해 각각 59.2%, 42.7% 감소하였다. 또한 유황은 모잘록병원균의 균사생장에도 영향을 미치는 것으로 확인되었는데, 접종 후 5 일째 R. solani의 균사생장이 68.4% 억제되었다.
Colony growth of Cylindrocarpon destructans, Fusarium solani and Rhizoctonia solani by the concentration of sulfur in PDA medium.

Effect of the concentration of sulfur on colony growth of Cylindrocarpon destructans, Fusarium solani and Rhizoctonia solani in vitro culture using PDA medium.
이와 같이 기내실험에서도 C. destructans와 F. solani로 오 염된 인삼 재작지 토양에 유황을 0.1 ~ 2.0% 농도로 처리하면 병원균의 생장을 억제할 수 있어 실제 포장실험에서도 병 방 제에 효과가 있을 것으로 예상할 수 있는데, Table 5에서와 같이 포장검정 결과 유황 1.0% 처리에서 묘삼의 지하부 생존 율이 가장 높았다. 그런데 기내에서 유황을 2.0% 처리하면 유 황 1.0% 처리보다 C. destructans와 F. solani의 균사 생육이 더 억제되어 묘삼의 지하부 생존율이 더 높을 것으로 예상되 었으나 묘삼의 지하부 생존율은 유황 1.0% 보다 더 낮았다. 이는 포장실험에서 유황의 살균작용 이외에 토양 pH와 EC의 급격한 변화 등과 같은 요인이 묘삼의 지하부 병해 발생에 영 향을 미쳤기 때문으로 생각된다 (Rahman and Punja, 2005).
감사의 글
본 연구는 농촌진흥청 국립원예특작과학원에서 주관하는 인 삼 연작장해 경감을 위한 기반기술 개발 및 실용화 연구(과제 번호: PJ008576)의 연구비 지원에 의해 이루어진 결과로 이에 감사드립니다.
REFERENCES
-
An, TJ, Shin, KS, Ahn, YS, Hur, M, Park, CB, Identification of fungal pathogen causing seedling rot ofLithospermum erythrorhizonand study on the optimum growing temperature for decreasing of the seedling rot, Korean Journal of Medicinal Crop Science, (2013), 21, p27-31.
[https://doi.org/10.7783/kjmcs.2013.21.1.27]

- Booth, CD, The genusCylindrocarpon, Mycological Papers, (1966), 104, p1-56.
- Cho, DH, Kang, JY, Yu, YH, Anastomosis group, pathogenicity and growth characteristics ofRhizoctonia solanicausing damping-off onPanax ginseng, Journal of Ginseng Research, (2004), 28, p183-190.
- Cho, DH, Ahn, IP, Yu, YH, Oh, SH, Lee, HS, Effect of incubation period, temperature and pH on mycelial growth ofCylindrocarpon destructans(Zinssm) Scholten causing root-rot of ginseng, Journal of Ginseng Research, (1995), 19, p181-187.
-
Choi, BY, Surh, JH, Influence of the number of sulfur application on the improvement of the chemical composition and quality of onions, Korean Journal of Food Science and Technology, (2013), 45, p478-487.
[https://doi.org/10.9721/kjfst.2013.45.4.478]

- Hong, YN, Introduction to plant physiology, (2012), 4th Ed, Seoul, Korea, Worldscience, p70.
- Hyun, DY, Yeon, BY, Lee, SW, Kang, SW, Hyun, GS, Kim, YC, Lee, KW, Kim, SM, Analysis of occurrence type of physiological disorder to soil chemical components in ginseng cultivated field, Korean Journal of Crop Science, (2009), 17, p439-444.
- Kang, SW, Yeon, BY, Hyeon, GS, Bae, YS, Lee, SW, Seong, NS, Changes of soil chemical properties and root injury ratio by progress years of post-harvest in continuous cropping soils of ginseng, Korean Journal of Medicinal Crop Science, (2007), 15, p157-161.
- Kim, KA, Rho, CW, Choi, KR, Hwang, HJ, Choi, HS, Quinone reductase inducer from radish leaf cultivated in the soil containing sulfur, Journal of the Korean Society of Food Science and Nutrition, (2004), 33, p946-950.
-
Kim, JS, Lee, YG, Kwon, M, Kim, JI, Lee, GJ, Lee, JT, Ryu, JS, Control of common scab of potato caused byStreptomyces spp. by soil pH adjustment and crop rotation, The Korean Society of Plant Pathology, (2012), 18, p117-122.
[https://doi.org/10.5423/rpd.2012.18.2.117]

- Kim, SI, Yoo, SJ, Kim, HG, Selection of antagonistic bacteria for biological control of ginseng diseases, The Korean Society of Plant Pathology, (1997), 13, p342-348.
- Kwak, YK, Kim, IS, Cho, MC, Lee, SC, Kim, S, Growth inhibition effect of environment-friendly agricultural materials inBotrytis cinereain vitro, Journal of Bio-Environment Control, (2012a), 21, p127-133.
- Kwak, YK, Kim, IS, Cho, MC, Lee, SC, Kim, S, Growth inhibition effect of environment-friendly agricultural materials inBotrytis cinereain vitro, Journal of Bio-Environment Control, (2012b), 21, p134-139.
-
Lee, SG, Fusarium species associated with ginseng(Panax ginseng) and their role in the root-rot of ginseng plant, The Korean Society of Plant Pathology, (2004), 10, p248-259.
[https://doi.org/10.5423/rpd.2004.10.4.248]

-
Lee, SW, Kim, GS, Hyun, DY, Kim, YB, Kim, JW, Kang, SW, Cha, SW, Comparison of growth characteristics and ginsenoside content of ginseng(Panax ginsengC. A. Meyer) cultivated with greenhouse and traditional shade facility, Korean Journal of Medicinal Crop Science, (2011), 19, p157-161.
[https://doi.org/10.7783/kjmcs.2011.19.3.157]

-
Lee, SW, Park, KC, Lee, SH, Park, JM, Jang, IB, Kim, KH, Soil chemical property and leaf mineral nutrient of ginseng cultivated in paddy field occurring leaf discoloration, Korean Journal of Medicinal Crop Science, (2013), 21, p289-295.
[https://doi.org/10.7783/kjmcs.2013.21.4.289]

-
Lee, SW, Park, KC, Lee, SH, Jang, IB, Park, JM, Kim, MR, Park, JM, Kim, KH, Effect of ferric and ferrous iron irrigation on brown-colored symptom of leaf inPanax ginsengC. A. Meyer, Korean Journal of Medicinal Crop Science, (2014), 22, p32-37.
[https://doi.org/10.7783/kjmcs.2014.22.1.32]

- Lee, SW, Hyun, DY, Park, CG, Kim, TS, Yeon, BY, Kim, CG, Cha, SW, Effect of soil moisture content on photosynthesis and yield ofPanax ginsengC. A. Meyer seedling, Korean Journal of Medicinal Crop Science, (2007), 15, p367-370.
-
Lee, SW, Kim, GS, Park, KC, Lee, SH, Jang, IB, Eo, JW, Cha, SW, Growth characteristics and ginsenosides content of 4-year-old ginseng by spraying lime-bordeaux mixture inPanax ginsengC. A. Meyer, Korean Journal of Medicinal Crop Science, (2012), 20, p89-93.
[https://doi.org/10.7783/kjmcs.2012.20.2.089]

- National Institute of Agricultural Science, Technology (NIAST), Methods of soil chemical analysis, (2000), Suwon, Korea, National Institute of Agricultural Science and Technology. Rural Development Adminstration, p103-130.
- Park, KJ, Cho, DH, Yu, YH, Oh, SH, Development of root rot and population variation of rhizomicrobes on 2 year-old ginseng cultivated in replanted fields, The Korean Society of Plant Pathology, (1997), 13, p262-268.
-
Proctor, RH, Hohn, TM, McCormick, SP, Reduced virulence ofGibberella zeaecaused by disruption of a trichothecene toxin biosynthetic gene, Molecular Plant-Microbe Interaction, (1995), 8, p593-601.
[https://doi.org/10.1094/mpmi-8-0593]

-
Punja, ZK, Fungal pathogens of American ginseng(Panax quinquefolium) in British Columbia, Canadian Journal of Plant Pathology, (1997), 19, p301-306.
[https://doi.org/10.1080/07060669709500528]

-
Rahman, M, Punja, ZK, Factors influencing development of root rot on ginseng caused byCylindrocarpon destructans, Phytopathology, (2005), 95, p1381-1390.
[https://doi.org/10.1094/phyto-95-1381]

- Rural Development Adminstration(RDA), Ginseng standard cultivation textbook, (2009), (Revised Edition), Suwon, Korea, Rural Development Adminstration, p94-100.
- Ryu, SH, Terminology dictionary for soil, (2000), Seoul, Korea, Seoul National University, p458-459.
-
Shin, JH, Yun, BD, Kim, HJ, Kim, SJ, Chung, DY, Soil environment and soil-borne plant pathogen causing root rot disease of ginseng, Korean Journal of Soil Science and Fertilizer, (2012), 45, p370-376.
[https://doi.org/10.7745/kjssf.2012.45.3.370]
